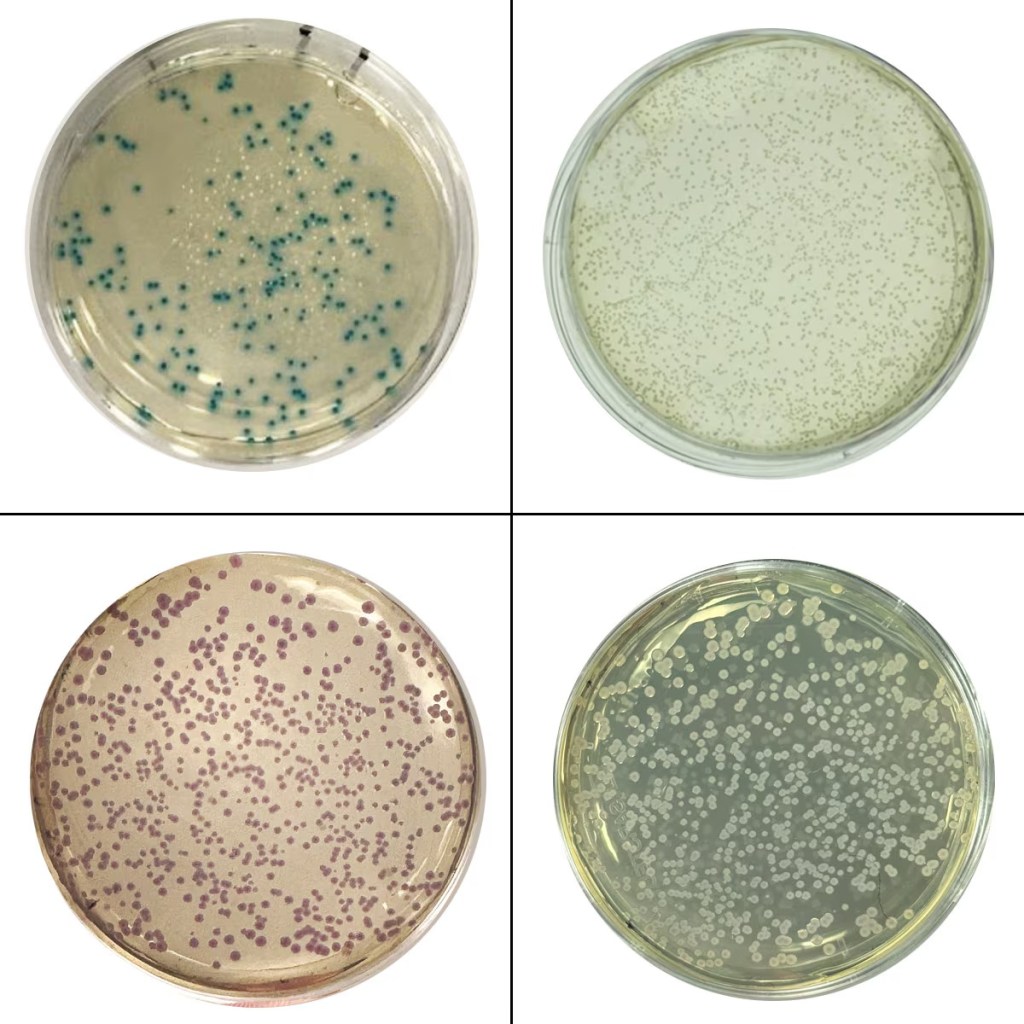
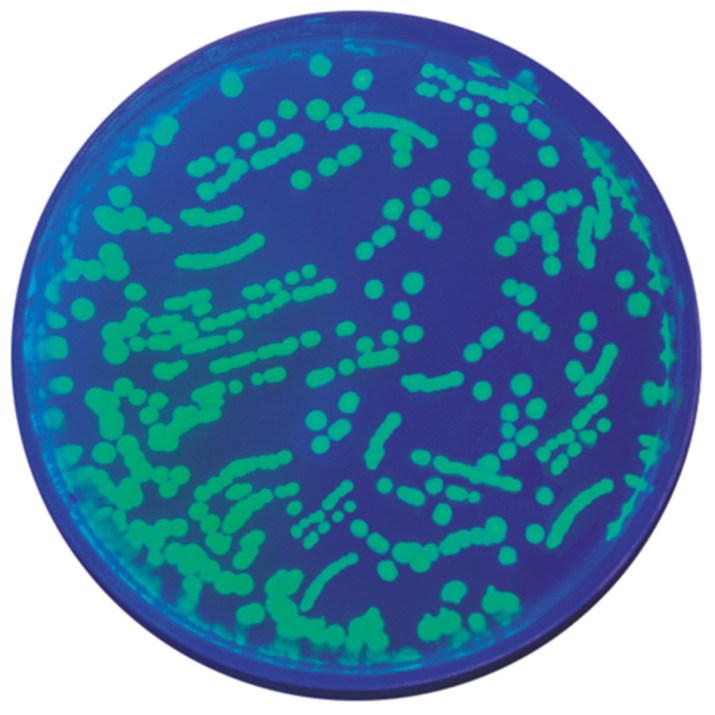

Genes are the fundamental units of heredity, carrying the instructions that dictate the development, functioning, and reproduction of all living organisms. Studying these genetic blueprints helps scientists unlock the mysteries of biological processes, understand diseases, and advance medical treatments. Scientists have developed a variety of methods and tools to unravel the complexities of the human genome and those of other organisms. Here’s a glimpse into the fascinating world of gene research and the methods scientists use to elucidate gene function.

DNA Sequencing
DNA sequencing allows scientists to determine the nucleotide sequence of an organism’s entire genetic material, known as their genome. A DNA extraction is performed first to obtain the genomic DNA from an organism. While there are many different methods for DNA sequencing, they require multiple copies of the DNA sample before sequencing can begin. Scientists utilize a technique known as polymerase chain reaction (PCR) to make large copies of a DNA template. Many modern methods of DNA sequencing utilize fluorescent labeled nucleotides. The template DNA is amplified via PCR in a unique reaction containing four different fluorescent labeled nucleotides which are analogous to the four base pairs incorporated into DNA. As the template is replicated, fluorescent nucleotides are incorporated into the strand. When a fluorescent nucleotide is incorporated into the new copy of the DNA strand, the size of the DNA fragment and fluorescence emission is measured. This data is then processed to construct an accurate nucleotide sequence for the template DNA.
DNA sequencing allows scientists to learn about the structure of genes and their connections to an organism’s observable characteristics. Scientists can also study the evolutionary relationships between species by comparing their DNA sequences. Because all living organisms evolved from a common ancestor, many species share variants of the same gene which serve similar functions. DNA sequencing has been used to determine if a person has a version of a gene that puts them at risk for a disease. For example, mutant variants of the retinoblastoma (RB) tumor suppressor gene are linked to childhood cancer of the eye. For those interested in cancer-linked gene detection check out Edvo-Kit 115.
Gene Editing
Gene editing involves precise alterations to an organism’s DNA and is utilized by researchers to study gene function. The primary method of gene editing today is known as CRISPR. CRISPR works by cutting a DNA sequence at a specific location in order to delete or insert a DNA sequence. This can be used to incorporate large segments of DNA, modify a single base pair in a gene or delete sections of DNA. These genetic modifications can have a variety of effects depending on the type of modification and function of the gene modified. Therefore, CRISPR can be used in many different ways when it comes to investigating gene function.
A typical experiment to investigate gene function involves inactivating a gene, either by deleting the nucleotides encoding the gene or by inserting additional nucleotides to disrupt the gene product. Once the gene is inactivated via CRISPR, the downstream effects of that mutation can be observed to learn about what the modified gene does. Scientists measure phenotypic changes in comparison to wild-type organisms to study the effect of these “knock out” mutations.
Model Organisms
A model organism is an organism that allows scientists to study fundamental questions that are hard to study directly in humans. Many organisms share genes which have similar functions to their human counterparts and can thus be used to investigate that genes function. Model organisms are useful because their genomes are smaller than humans and have shorter lifespans. This makes their genome easier to fully characterize and gives researchers the ability to study human gene mutations in non-human organisms. For example, genetic studies using Drosophila melanogaster have led to major breakthroughs in research related to Alzheimer’s disease in humans, as about 75% of the genes that cause disease in humans have homologs in Drosophilia. For those interested in genetic engineering of model organisms check the kits below: